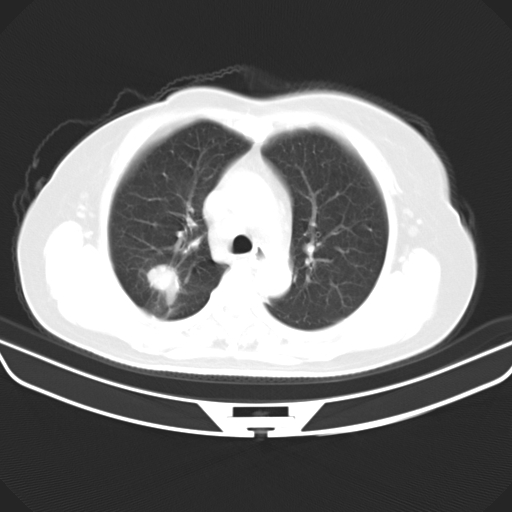
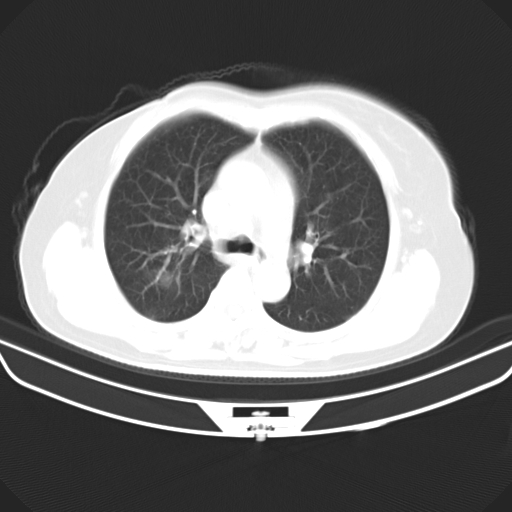
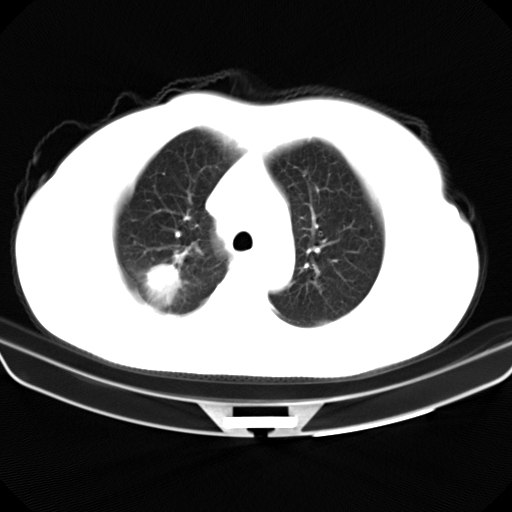
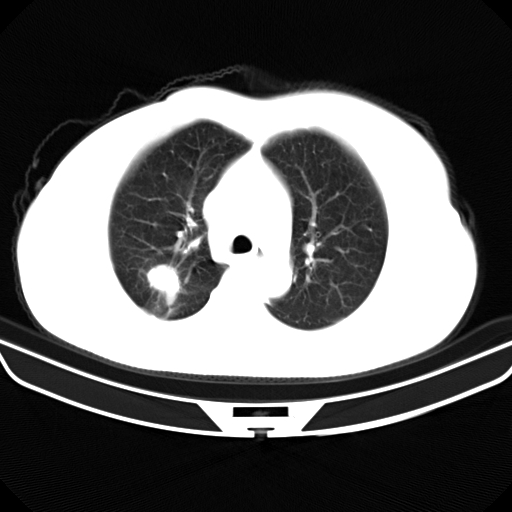
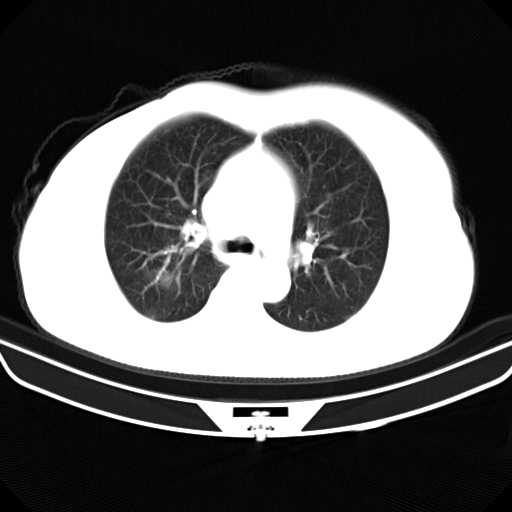

以下是引用zjzjr在2007-3-23 13:28:00的发言:[br]右肺上叶后段可见一结节状高密度影,可见毛刺征,胸膜凹陷征及血管导入征,纵隔内可见肿大淋巴结影.考虑右肺上叶周围型肺癌伴纵隔淋巴结转移.
以下是引用hhcckk在2007-3-23 14:46:00的发言:[br][br]
以下是引用jone-baby在2007-3-23 15:16:00的发言:[br][quote]以下是引用hhcckk在2007-3-23 14:46:00的发言:[br][br]

以下是引用zjzjr在2007-3-23 13:28:00的发言:[br]右肺上叶后段可见一结节状高密度影,可见毛刺征,胸膜凹陷征及血管导入征,气管前腔静脉后可见肿大淋巴结影.考虑右肺上叶周围型肺癌伴纵隔淋巴结转移.
以下是引用hhcckk在2007-3-23 14:46:00的发言:[br][br]
| 欢迎光临 医影在线 (http://bbs.radida.com/bbs/) | Powered by Discuz! X3.2 |